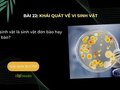
Vi sinh vật là sinh vật đơn bào hay đa bào?

Hãy cho biết các phương pháp nghiên cứu vi sinh vật thường thấy
Hãy cho biết các phương pháp nghiên cứu vi sinh vật thường thấy trong phòng thí nghiệm. Trả lời câu hỏi 6 trang 108 sách giáo khoa Sinh học 10 Chân trời sáng tạo

 Bộ môn: Văn
Bộ môn: Văn Lớp: 12
Lớp: 12
Hãy cho biết các phương pháp nghiên cứu vi sinh vật thường thấy trong phòng thí nghiệm. Trả lời câu hỏi 6 trang 108 sách giáo khoa Sinh học 10 Chân trời sáng tạo

Hãy lập bảng so sánh các kiểu dinh dưỡng khác nhau ở vi sinh vật. Trả lời câu hỏi luyện tập 2 trang 108 sách giáo khoa Sinh học 10 Chân trời sáng tạo

Hãy cho biết vi sinh vật quang tự dưỡng và quang dị dưỡng sử dụng nguồn nguyên liệu nào cho sinh trưởng và phát triển. Trả lời câu hỏi 5 trang 107 sách giáo khoa Sinh học 10 CTST

Hãy sắp xếp các loài vi sinh vật trong Hình 22.4 vào các kiểu dinh dưỡng cho phù hợp. Trả lời câu hỏi 4 trang 107 sách giáo khoa Sinh học 10 Chân trời sáng tạo

Halobacteria, trùng Amip, Escherichia coli, Chlorella là những vi sinh vật thuộc nhóm nào trong Hình 22.3? Trả lời câu hỏi 3 trang 107 sách giáo khoa Sinh học 10 CTST

Hãy cho biết những đặc điểm của vi sinh vật. Trả lời câu hỏi luyện tập 1 trang 107 sách giáo khoa Sinh học 10 Chân trời sáng tạo

Quan sát Hình 22.2 và cho biết vi sinh vật có kích thước như thế nào? Trả lời câu hỏi 2 trang 106 sách giáo khoa Sinh học 10 Chân trời sáng tạo
Vi sinh vật là sinh vật đơn bào hay đa bào? Trả lời câu hỏi 1 trang 106 sách giáo khoa Sinh học 10 Chân trời sáng tạo

Hình 4 mô tả quá trình nhân bản vô tính ở cừu. Hãy cho biết tên gọi của các giai đoạn (A), (B), (C). Trả lời câu hỏi 6 trang 105 sách giáo khoa Sinh học 10 Chân trời sáng tạo

Chọn ra các ý phù hợp với nguyên phân, giảm phân. Trả lời câu hỏi 5 trang 105 sách giáo khoa Sinh học 10 Chân trời sáng tạo